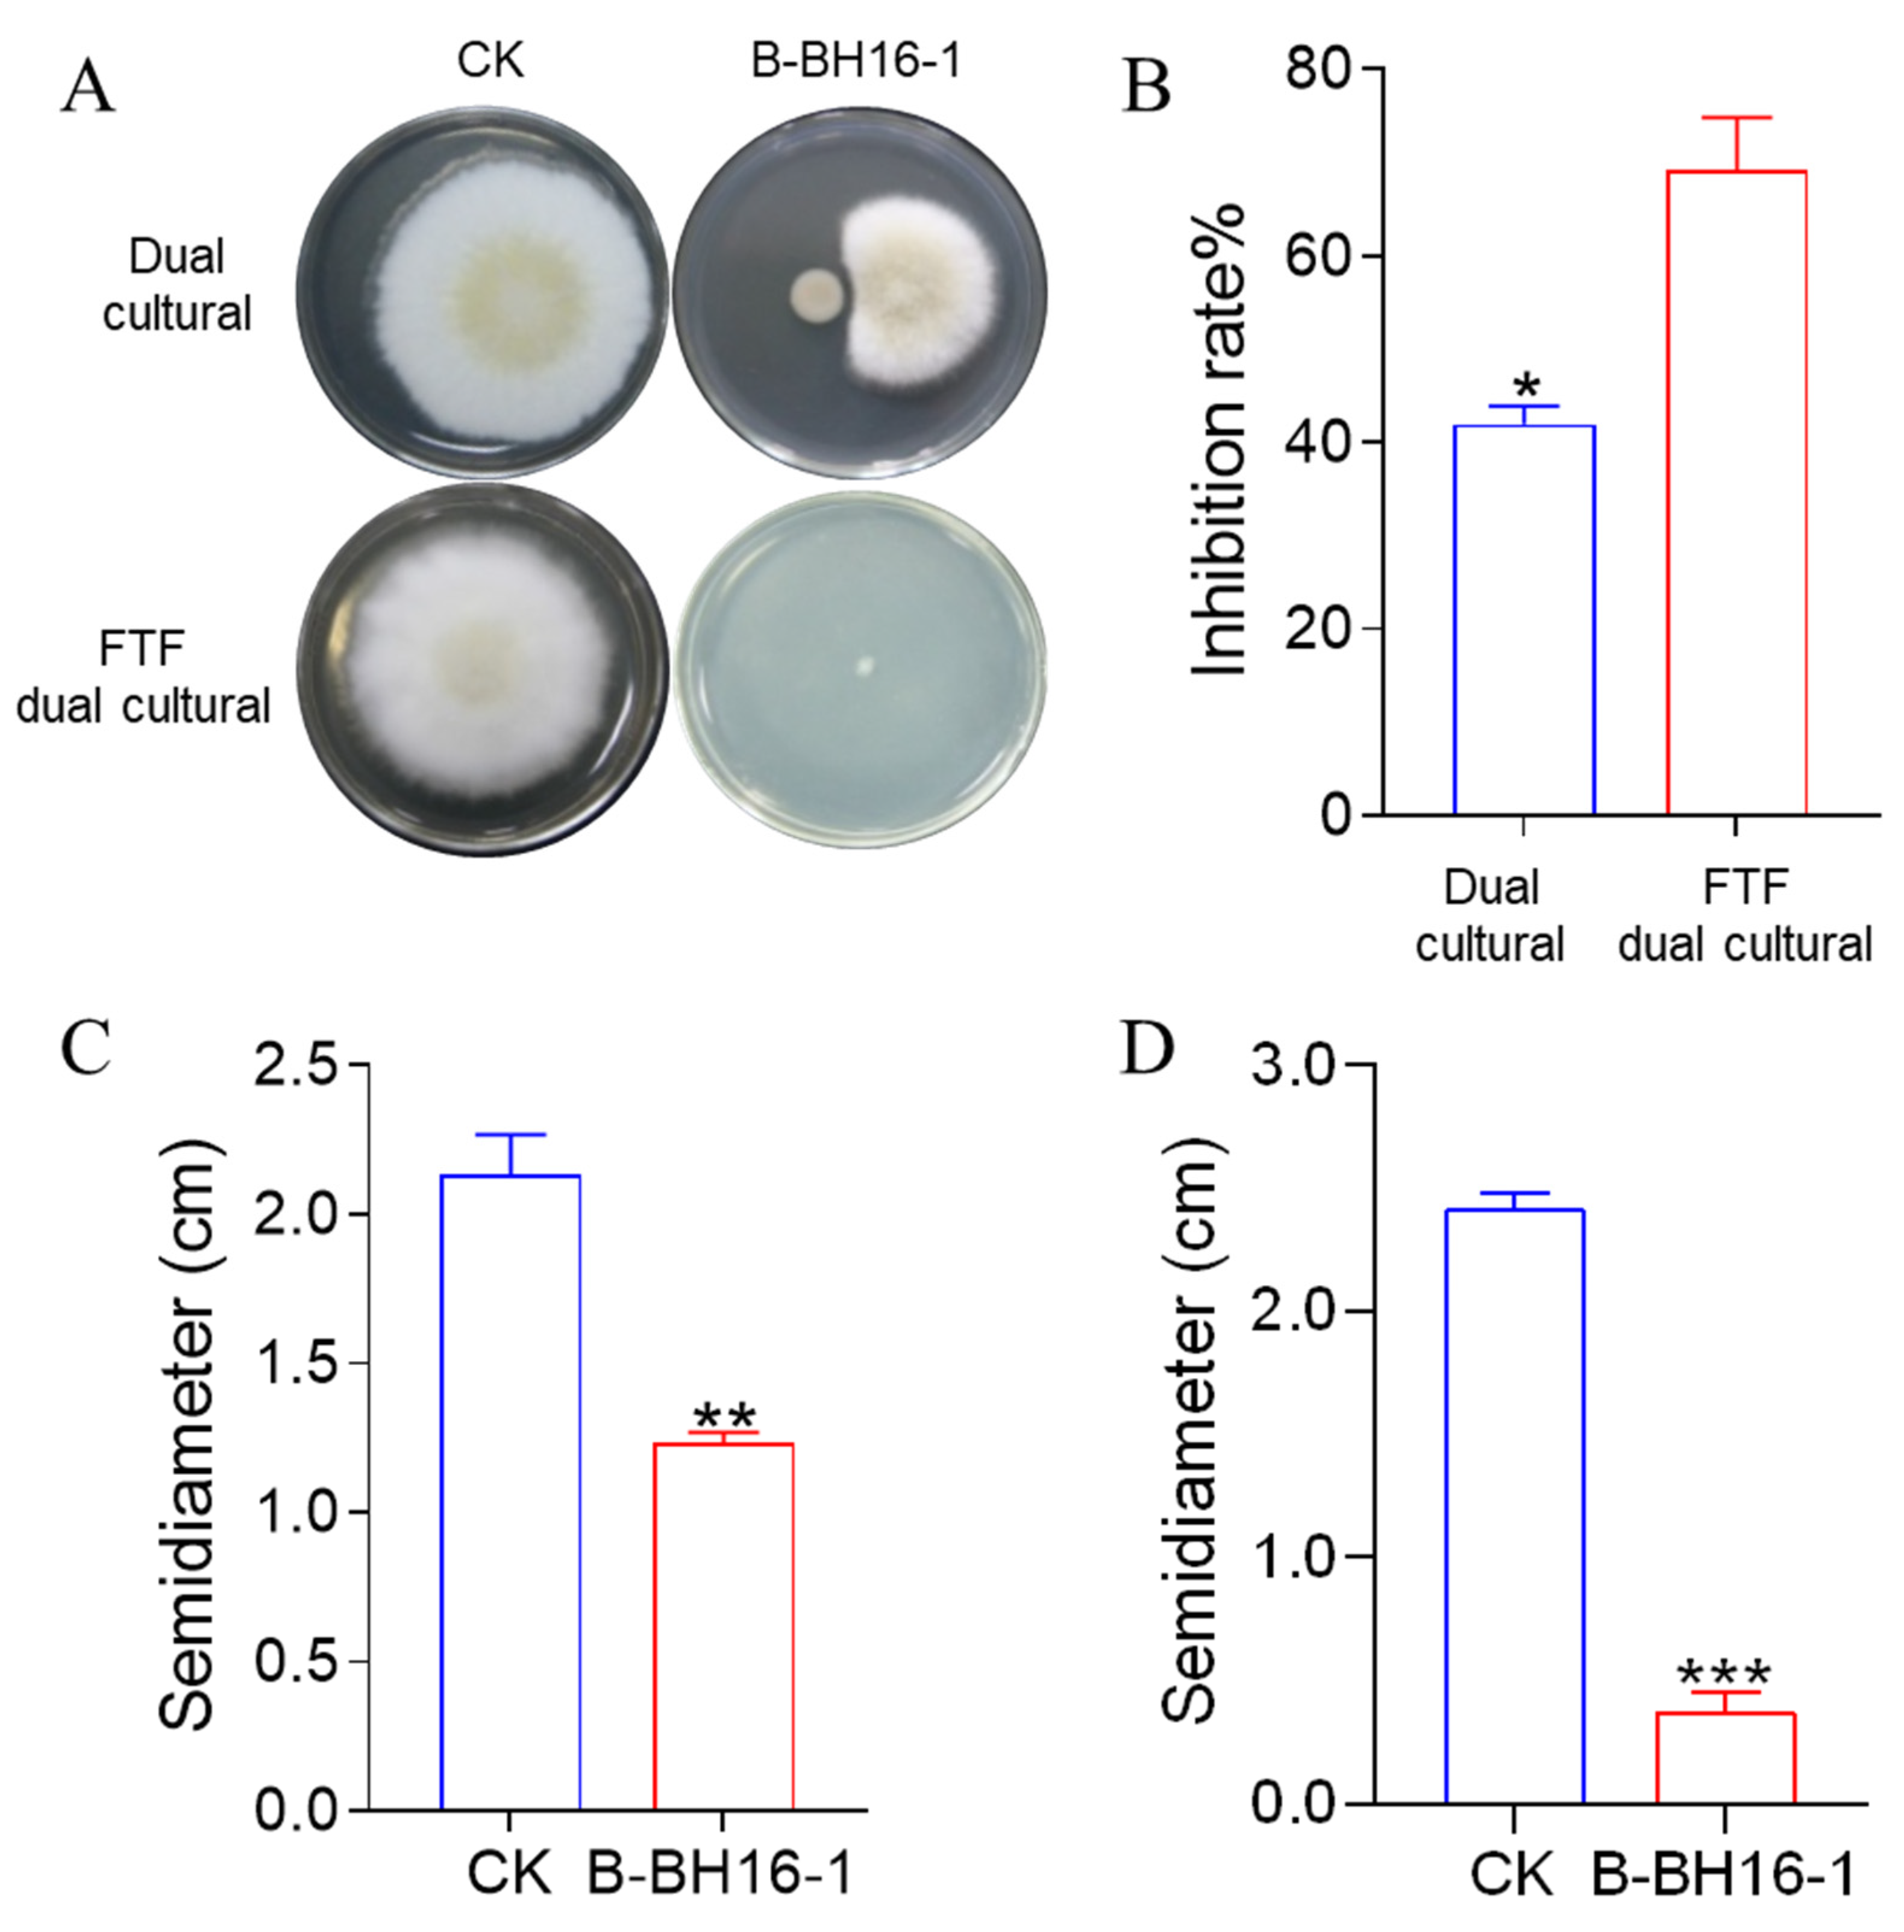
Toxins 15 00077 g002
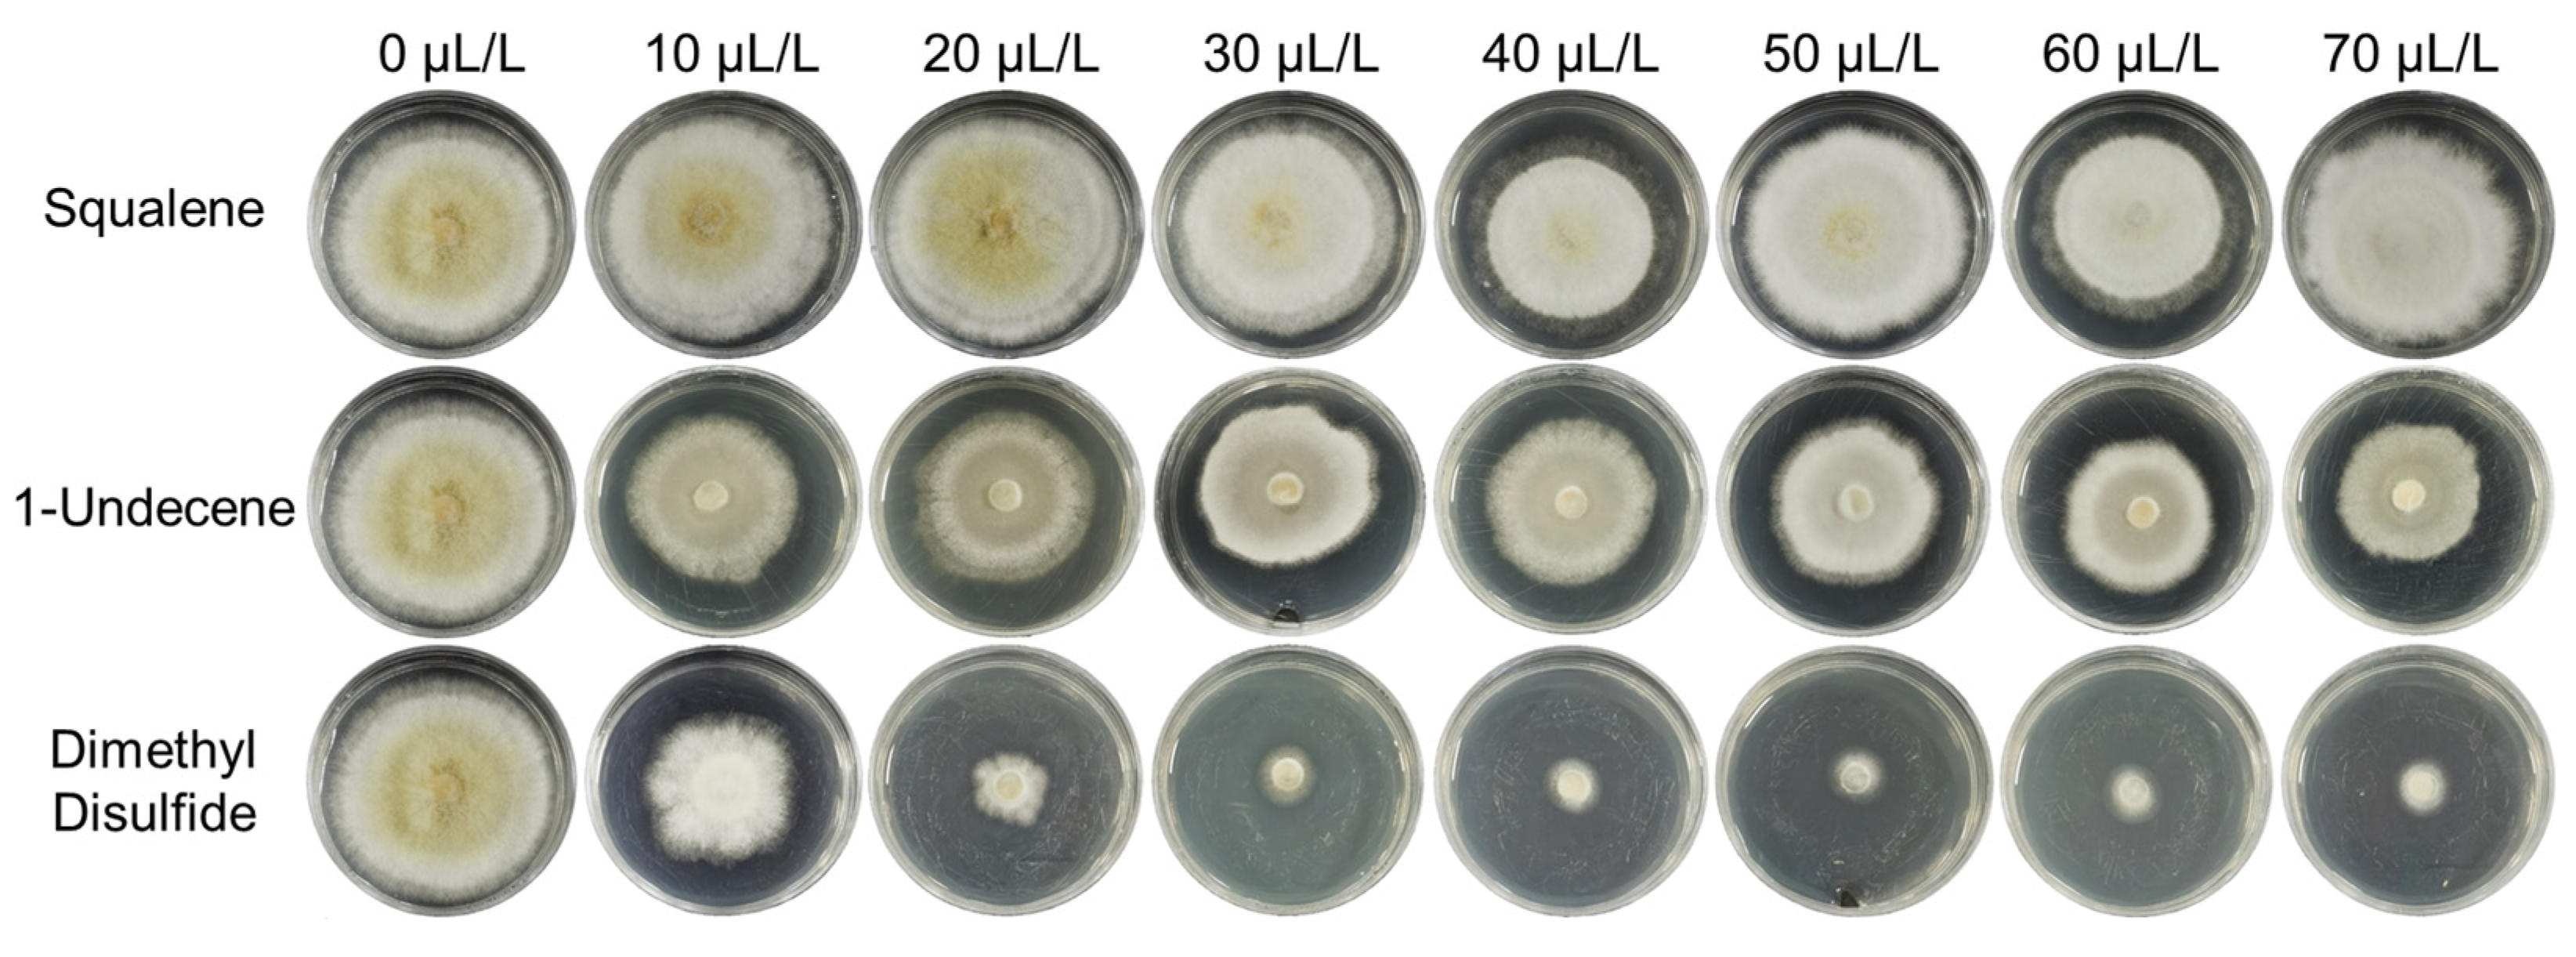
Toxins 15 00077 g006

Volatiles from Pseudomonas palleroniana Strain B-BH16-1 Suppress Aflatoxin Production and Growth of Aspergillus flavus on Coix lacryma-jobi during Storage
Abstract
1. Introduction
2. Results
2.1. Identification of Antifungal Bacterial Strain B-BH16-1
2.2. Antifungal Activity of P. palleroniana Strain B-BH16-1 via the Emission of Volatiles and the Secretion of Diffusible Substances
2.3. Inhibitory Effect of P. palleroniana Strain B-BH16-1 on the Spore Formation and Mycelium Malformation of A. flavus
2.4. Biocontrol Activity of the P. palleroniana Strain on A. flavus Growth and Aflatoxin Biosynthesis in Storage
2.5. Identification of Volatiles from Strain B-BH16-1
2.6. Minimal Inhibitory Concentration Analysis of Volatiles from P. palleroniana Strain B-BH16-1 against A. flavus
3. Discussion
4. Conclusions
5. Materials and Methods
5.1. Microorganisms and Plants
5.2. Identification of Strain B-BH16-1
5.3. Antagonistic Activity of Volatiles from Strain B-BH16-1 against A. flavus Mycelia
5.4. Control of A. flavus and its Aflatoxins on Semen Coicis Using Strain B-BH16-1
5.5. RNA Extraction and RT-qPCR Analysis
5.6. Quantitative Analysis of Aflatoxins in Semen Coicis
5.7. Microscopic Structural Analysis of A. flavus Cells and Sporulation when Affected by P. palleroniana Strain B-BH16-1
5.8. Volatile Identification and Inhibitory Analysis
5.9. Data Analysis
Author Contributions
Funding
Institutional Review Board Statement
Informed Consent Statement
Data Availability Statement
Acknowledgments
Conflicts of Interest
References
- Du, J.; Yin, G.; Hu, Y.; Shi, S.; Jiang, J.; Song, X.; Zhang, Z.; Wei, Z.; Tang, C.; Lyu, H. Coicis semen protects against focal cerebral ischemia-reperfusion injury by inhibiting oxidative stress and promoting angiogenesis via the tgfβ/alk1/smad1/5 signaling pathway. Aging 2020, 13, 877–893. [Google Scholar] [CrossRef]
- Zhang, C.; Zhang, W.; Shi, R.; Tang, B.; Xie, S. Coix lachryma-jobi extract ameliorates inflammation and oxidative stress in a complete freund’s adjuvant-induced rheumatoid arthritis model. Pharm. Biol. 2019, 57, 792–798. [Google Scholar] [CrossRef]
- Ashiq, S.; Hussain, M.; Ahmad, B. Natural occurrence of mycotoxins in medicinal plants: A review. Fungal Genet. Biol. 2014, 66, 1–10. [Google Scholar] [CrossRef] [PubMed]
- Qin, L.; Jiang, J.Y.; Zhang, L.; Dou, X.W.; Yang, M.H. Occurrence and analysis of mycotoxins in domestic chinese herbal medicines. Mycology 2020, 11, 126–146. [Google Scholar] [CrossRef]
- Thakare, D.; Zhang, J.; Wing, R.A.; Cotty, P.J.; Schmidt, M.A. Aflatoxin-free transgenic maize using host-induced gene silencing. Sci. Adv. 2017, 3, e1602382. [Google Scholar] [CrossRef] [PubMed]
- Choi, S.; Jun, H.; Bang, J.; Chung, S.-H.; Kim, Y.; Kim, B.-S.; Kim, H.; Beuchat, L.R.; Ryu, J.-H. Behaviour of aspergillus flavus and fusarium graminearum on rice as affected by degree of milling, temperature, and relative humidity during storage. Food Microbiol. 2015, 46, 307–313. [Google Scholar] [CrossRef]
- Chulze, S.N.; Palazzini, J.M.; Torres, A.M.; Barros, G.; Ponsone, M.L.; Geisen, R.; Schmidt-Heydt, M.; Kohl, J. Biological control as a strategy to reduce the impact of mycotoxins in peanuts, grapes and cereals in argentina. Food Addit. Contaminants. Part A 2015, 32, 471–479. [Google Scholar] [CrossRef]
- Al-Wadai, A.S.; Al-Othman, M.R.; Mahmoud, M.A.; Abd El-Aziz, A.R. Molecular characterization of aspergillus flavus and aflatoxin contamination of wheat grains from saudi arabia. Genet. Mol. Res. 2013, 12, 3335–3352. [Google Scholar] [CrossRef]
- Lee, D.; Lyu, J.; Lee, K.-G. Analysis of aflatoxins in herbal medicine and health functional foods. Food Control 2015, 48, 33–36. [Google Scholar] [CrossRef]
- Tajkarimi, M.; Shojaee, M.H.; Yazdanpanah, H.; Ibrahim, S.A. Aflatoxin in agricultural commodities and herbal medicine. Aflatoxins Biochem. Mol. Biol. 2011, 367–396. [Google Scholar] [CrossRef]
- Tassaneeyakul, W.; Razzazi-Fazeli, E.; Porasuphatana, S.; Bohm, J. Contamination of aflatoxins in herbal medicinal products in thailand. Mycopathologia 2004, 158, 239–244. [Google Scholar] [CrossRef]
- Wei, R.; Qiu, F.; Kong, W.; Wei, J.; Yang, M.; Luo, Z.; Qin, J.; Ma, X. Co-occurrence of aflatoxin b1, b2, g1, g2 and ochrotoxin a in glycyrrhiza uralensis analyzed by hplc-ms/ms. Food Control 2013, 32, 216–221. [Google Scholar] [CrossRef]
- Rangsipanuratn, W.; Kammarnjassadakul, P.; Janwithayanuchit, I.; Paungmoung, P.; Ngamurulert, S.; Sriprapun, M.; Yangen, S.; Soottitantawat, V.; Sandee, A. Detection of microbes, aflatoxin and toxic heavy metals in chinese medicinal herbs commonly consumed in thailand. Pharm. Sci. Asia 2017, 44, 162–171. [Google Scholar] [CrossRef]
- Hussein, H.S.; Brasel, J.M. Toxicity, metabolism, and impact of mycotoxins on humans and animals. Toxicology 2001, 167, 101–134. [Google Scholar] [CrossRef]
- Wu, F. Global impacts of aflatoxin in maize: Trade and human health. World Mycotoxin J. 2015, 8, 137–142. [Google Scholar] [CrossRef]
- Gong, A.-D.; Dong, F.-Y.; Hu, M.-J.; Kong, X.-W.; Wei, F.-F.; Gong, S.-J.; Zhang, Y.-M.; Zhang, J.-B.; Wu, A.-B.; Liao, Y.-C. Antifungal activity of volatile emitted from enterobacter asburiae vt-7 against aspergillus flavus and aflatoxins in peanuts during storage. Food Control 2019, 106, 106718. [Google Scholar] [CrossRef]
- Jiang, C.; Li, Z.; Shi, Y.; Guo, D.; Pang, B.; Chen, X.; Shao, D.; Liu, Y.; Shi, J. Bacillus subtilis inhibits aspergillus carbonarius by producing iturin a, which disturbs the transport, energy metabolism, and osmotic pressure of fungal cells as revealed by transcriptomics analysis. Int. J. Food Microbiol. 2020, 330, 108783. [Google Scholar] [CrossRef] [PubMed]
- Chaves-López, C.; Serio, A.; Gianotti, A.; Sacchetti, G.; Ndagijimana, M.; Ciccarone, C.; Stellarini, A.; Corsetti, A.; Paparella, A. Diversity of food-borne bacillus volatile compounds and influence on fungal growth. J. Appl. Microbiol. 2015, 119, 487–499. [Google Scholar] [CrossRef] [PubMed]
- Farzaneh, M.; Shi, Z.Q.; Ahmadzadeh, M.; Hu, L.B.; Ghassempour, A. Inhibition of the aspergillus flavus growth and aflatoxin b1 contamination on pistachio nut by fengycin and surfactin-producing bacillus subtilis utbsp1. Plant Pathol. J. 2016, 32, 209–215. [Google Scholar] [CrossRef]
- Tayel, A.A.; El-Tras, W.F.; Moussa, S.H.; El-Agamy, M.A. Antifungal action of pichia anomala against aflatoxigenic aspergillus flavus and its application as a feed supplement. J. Sci. Food Agric. 2013, 93, 3259–3263. [Google Scholar] [CrossRef]
- Csóka, M.; Geosel, A.; Amtmann, M.; Korany, K. Volatile composition of some cultivated and wild culinary-medicinal mushrooms from hungary. Int. J. Med. Mushrooms 2017, 19, 433–443. [Google Scholar] [CrossRef]
- Zhang, M.; Zhao, R.; Wang, D.; Wang, L.; Zhang, Q.; Wei, S.; Lu, F.; Peng, W.; Wu, C. Ginger (zingiber officinale rosc.) and its bioactive components are potential resources for health beneficial agents. Phytother. Res. 2021, 35, 711–742. [Google Scholar] [CrossRef]
- Donato, R.; Sacco, C.; Pini, G.; Bilia, A.R. Antifungal activity of different essential oils against malassezia pathogenic species. J. Ethnopharmacol. 2020, 249, 112376. [Google Scholar] [CrossRef]
- Salehi, B.; Mishra, A.P.; Shukla, I.; Sharifi-Rad, M.; Contreras, M.D.M.; Segura-Carretero, A.; Fathi, H.; Nasrabadi, N.N.; Kobarfard, F.; Sharifi-Rad, J. Thymol, thyme, and other plant sources: Health and potential uses. Phytother. Res. 2018, 32, 1688–1706. [Google Scholar] [CrossRef] [PubMed]
- Brochot, A.; Guilbot, A.; Haddioui, L.; Roques, C. Antibacterial, antifungal, and antiviral effects of three essential oil blends. MicrobiologyOpen 2017, 6, e00459. [Google Scholar] [CrossRef] [PubMed]
- Gong, A.D.; Li, H.P.; Shen, L.; Zhang, J.B.; Wu, A.B.; He, W.J.; Yuan, Q.S.; He, J.D.; Liao, Y.C. The shewanella algae strain ym8 produces volatiles with strong inhibition activity against aspergillus pathogens and aflatoxins. Front. Microbiol. 2015, 6, 1091–1102. [Google Scholar] [CrossRef] [PubMed]
- Gong, A.D.; Li, H.P.; Yuan, Q.S.; Song, X.S.; Yao, W.; He, W.J.; Zhang, J.B.; Liao, Y.C. Antagonistic mechanism of iturin a and plipastatin a from bacillus amyloliquefaciens s76-3 from wheat spikes against fusarium graminearum. PLoS ONE 2015, 10, e0116871. [Google Scholar] [CrossRef] [PubMed]
- Anastassiadou, M.; Arena, M.; Auteri, D.; Barmaz, S.; Brancato, A.; Bura, L.; Carrasco Cabrera, L.; Chaideftou, E.; Chiusolo, A.; Court Marques, D.; et al. Peer review of the pesticide risk assessment of the active substance dimethyl disulfide. EFSA J. Eur. Food Saf. Auth. 2019, 17, e05905. [Google Scholar]
- Ling, S.; Qiu, H.; Xu, J.; Gu, Y.; Yu, J.; Wang, W.; Liu, J.; Zeng, X. Volatile dimethyl disulfide from guava plants regulate developmental performance of asian citrus psyllid through activation of defense responses in neighboring orange plants. Int. J. Mol. Sci. 2022, 23, 10271. [Google Scholar] [CrossRef]
- Huang, C.J.; Tsay, J.F.; Chang, S.Y.; Yang, H.P.; Wu, W.S.; Chen, C.Y. Dimethyl disulfide is an induced systemic resistance elicitor produced by bacillus cereus c1l. Pest Manag. Sci. 2012, 68, 1306–1310. [Google Scholar] [CrossRef]
- Tyagi, S.; Lee, K.J.; Shukla, P.; Chae, J.C. Dimethyl disulfide exerts antifungal activity against sclerotinia minor by damaging its membrane and induces systemic resistance in host plants. Sci. Rep. 2020, 10, 6547. [Google Scholar] [CrossRef]
- Hao, B.; Ren, L.; Huang, B.; Tang, X.; Cheng, H.; Yan, D.; Li, Y.; Cao, A.; Ouyang, C.; Wang, Q. 2-hydroxypropyl-β-cyclodextrin encapsulates dimethyl disulfide producing a controlled release formulation. Sci. Total Environ. 2021, 773, 145293. [Google Scholar] [CrossRef]
- Yan, D.; Cao, A.; Wang, Q.; Li, Y.; Canbin, O.; Guo, M.; Guo, X. Dimethyl disulfide (dmds) as an effective soil fumigant against nematodes in china. PLoS ONE 2019, 14, e0224456. [Google Scholar] [CrossRef]
- Gfeller, A.; Fuchsmann, P.; De Vrieze, M.; Gindro, K.; Weisskopf, L. Bacterial volatiles known to inhibit phytophthora infestans are emitted on potato leaves by pseudomonas strains. Microorganisms 2022, 10, 1510. [Google Scholar] [CrossRef]
- Prakash, D.; Ms, A.; Radhika, B.; Venkatesan, R.; Chalasani, S.H.; Singh, V. 1-undecene from pseudomonas aeruginosa is an olfactory signal for flight-or-fight response in caenorhabditis elegans. EMBO J. 2021, 40, e106938. [Google Scholar] [CrossRef]
- Wang, Z.; Zhong, T.; Chen, X.; Yang, B.; Du, M.; Wang, K.; Zalán, Z.; Kan, J. Potential of volatile organic compounds emitted by pseudomonas fluorescens zx as biological fumigants to control citrus green mold decay at postharvest. J. Agric. Food Chem. 2021, 69, 2087–2098. [Google Scholar] [CrossRef]
- Montes-Osuna, N.; Cernava, T.; Gómez-Lama Cabanás, C.; Berg, G.; Mercado-Blanco, J. Identification of volatile organic compounds emitted by two beneficial endophytic pseudomonas strains from olive roots. Plants 2022, 11, 318. [Google Scholar] [CrossRef]
- Reddy, L.H.; Couvreur, P. Squalene: A natural triterpene for use in disease management and therapy. Adv. Drug Deliv. Rev. 2009, 61, 1412–1426. [Google Scholar] [CrossRef]
- Kim, S.K.; Karadeniz, F. Biological importance and applications of squalene and squalane. Adv. Food Nutr. Res. 2012, 65, 223–233. [Google Scholar]
- Sun, D.; Mao, J.; Wei, H.; Zhang, Q.; Cheng, L.; Yang, X.; Li, P. Efficient prevention of aspergillus flavus spores spread in air using plasmonic Ag-AgCl/α-Fe2O3 under visible light irradiation. ACS Appl. Mater. Interfaces 2022, 14, 28021–28032. [Google Scholar] [CrossRef]
- Olanya, O.M.; Hoyos, G.M.; Tiffany, L.H.; McGee, D.C. Waste corn as a point source of inoculum for aspergillus flavus in the corn agroecosystem. Plant Dis. 1997, 81, 576–581. [Google Scholar] [CrossRef]
- Yuan, Q.S.; Yang, P.; Wu, A.B.; Zuo, D.Y.; He, W.J.; Guo, M.W.; Huang, T.; Li, H.P.; Liao, Y.C. Variation in the microbiome, trichothecenes, and aflatoxins in stored wheat grains in wuhan, china. Toxins 2018, 10, 171. [Google Scholar] [CrossRef]
- Yu, S.; Teng, C.; Liang, J.; Song, T.; Dong, L.; Bai, X.; Jin, Y.; Qu, J. Characterization of siderophore produced by pseudomonas syringae baf.1 and its inhibitory effects on spore germination and mycelium morphology of fusarium oxysporum. J. Microbiol. 2017, 55, 877–884. [Google Scholar] [CrossRef]
- Landa, B.B.; Mavrodi, O.V.; Raaijmakers, J.M.; McSpadden Gardener, B.B.; Thomashow, L.S.; Weller, D.M. Differential ability of genotypes of 2,4-diacetylphloroglucinol-producing pseudomonas fluorescens strains to colonize the roots of pea plants. Appl. Environ. Microbiol. 2002, 68, 3226–3237. [Google Scholar] [CrossRef]
- Isabelle, V.G.; Alexey, N.; Luis, A.; Peter, L.; Gérard, B.; Maria, P.T.; Pierre, C.; Christoph, K.; Martine, C.; Bruno, L. Association of hemolytic activity of pseudomonas entomophila, a versatile soil bacterium, with cyclic lipopeptdee production. Appl. Environ. Microbiol. 2010, 76, 910–921. [Google Scholar]
- Kuiper, I.; Lagendijk, E.L.; Pickford, R.; Derrick, J.P.; Lamers, G.E.; Thomasoates, J.E.; Lugtenberg, B.J.; Bloemberg, G.V. Characterization of two pseudomonas putida lipopeptide biosurfactants, putisolvin i and ii, which inhibit biofilm formation and break down existing biofilms. Mol. Microbiol. 2004, 51, 97–113. [Google Scholar] [CrossRef]
- Yuan, Q.-S.; Wang, L.; Wang, H.; Wang, X.; Jiang, W.; Ou, X.; Xiao, C.; Gao, Y.; Xu, J.; Yang, Y.; et al. Pathogen-mediated assembly of plant-beneficial bacteria to alleviate fusarium wilt in pseudostellaria heterophylla. Front. Microbiol. 2022, 13, 842372–842386. [Google Scholar] [CrossRef]
- Yuan, Q.S.; Xu, J.; Jiang, W.K.; Ou, X.H.; Wang, H.; Guo, L.P.; Xiao, C.H.; Wang, Y.H.; Wang, X.; Kang, C.Z.; et al. Insight to shape of soil microbiome during the ternary cropping system of gastradia elata. BMC Microbiol. 2020, 20, 108. [Google Scholar] [CrossRef]
- Cheng, W.; Li, H.P.; Zhang, J.B.; Du, H.J.; Wei, Q.Y.; Huang, T.; Yang, P.; Kong, X.W.; Liao, Y.C. Tissue-specific and pathogen-inducible expression of a fusion protein containing a fusarium-specific antibody and a fungal chitinase protects wheat against fusarium pathogens and mycotoxins. Plant Biotechnol. J. 2015, 13, 664–674. [Google Scholar] [CrossRef]
- Cheng, W.; Song, X.S.; Li, H.P.; Cao, L.H.; Sun, K.; Qiu, X.L.; Xu, Y.B.; Yang, P.; Huang, T.; Zhang, J.B.; et al. Host-induced gene silencing of an essential chitin synthase gene confers durable resistance to fusarium head blight and seedling blight in wheat. Plant Biotechnol. J. 2015, 13, 1335–1345. [Google Scholar] [CrossRef]

| Gene Name | Gene Functions | Forward Primer | Reverse Primer |
|---|---|---|---|
| NsdD | sexual development transcription factor NsdD | CCGCCTATGAATACAGTGCTCCTAC | GACCCGCAAGTCCATTCCT |
| FlbC | C2H2 conidiation transcription factor FlbC | ACTGGTGAAAAGCGTAAGTTCTAAG | GAACCTTCTTGTGCCGACGA |
| FlbD | MYB family conidiophore development protein FlbD | ATGATTGAGCGGATGGTGAAC | GACCATTGAAAGTGCGTGAGAT |
| Csd1 | C-3 sterol dehydrogenase--C-4 decarboxylase Csd1 | ACTCCCTCTTCGCCCTTCA | AGCCACCGACCACCAAAAC |
| Csd2 | C-3 sterol dehydrogenase--C-4 decarboxylase family protein Csd2 | TTGGCAATGGGCAGAACC | CCGCTGGAAGTCCCAAAAG |
| Sam1 | S-adenosyl-methionine-sterol-C- methyltransferase putative Sam1 | ATGAAGAGTCCATTGCCGAACA | TCCTGGACGATGAAGCGGTT |
| Csr1 | C-14 sterol reductase Csr1 | CAACTCAACCCCGAACTTAGAC | GGATGTTCCACCCAAGCAAA |
| Csr2 | C-14 sterol reductase Csr2 | TCACTCGTGCCTTCCCTTTG | TAGACAGGGGAGCCCGACAA |
| β-Tubulin | Endogenous control, reference gene | TCTTCATGGTTGGCTTCGCT | CTTGGGTCGAACATCTGCT |
| aflS | aflS | GGTCGTGCATGTGCGAATC | GAGGGCAACAACCAGTGAGG |
| aflR | aflR | GCACCCTGTCTTCCCTAACA | ACGACCATGCTCAGCAAGTA |
| OMTB | OMTB | ATCAAGGAGACAGGTCCCCAA | GCAGTCCTTGTTAGAGGTGATA |
Disclaimer/Publisher’s Note: The statements, opinions and data contained in all publications are solely those of the individual author(s) and contributor(s) and not of MDPI and/or the editor(s). MDPI and/or the editor(s) disclaim responsibility for any injury to people or property resulting from any ideas, methods, instructions or products referred to in the content. |
© 2023 by the authors. Licensee MDPI, Basel, Switzerland. This article is an open access article distributed under the terms and conditions of the Creative Commons Attribution (CC BY) license (https://creativecommons.org/licenses/by/4.0/).
Share and Cite
Zhou, S.; Yuan, Q.-S.; Wang, X.; Jiang, W.; Ou, X.; Yang, C.; Gao, Y.; Wang, Y.; Guo, L.; Huang, L.; et al. Volatiles from Pseudomonas palleroniana Strain B-BH16-1 Suppress Aflatoxin Production and Growth of Aspergillus flavus on Coix lacryma-jobi during Storage. Toxins 2023, 15, 77. https://doi.org/10.3390/toxins15010077
Zhou S, Yuan Q-S, Wang X, Jiang W, Ou X, Yang C, Gao Y, Wang Y, Guo L, Huang L, et al. Volatiles from Pseudomonas palleroniana Strain B-BH16-1 Suppress Aflatoxin Production and Growth of Aspergillus flavus on Coix lacryma-jobi during Storage. Toxins. 2023; 15(1):77. https://doi.org/10.3390/toxins15010077
Chicago/Turabian StyleZhou, Shihua, Qing-Song Yuan, Xiaoai Wang, Weike Jiang, Xiaohong Ou, Changgui Yang, Yanping Gao, Yanhong Wang, Lanping Guo, Luqi Huang, and et al. 2023. "Volatiles from Pseudomonas palleroniana Strain B-BH16-1 Suppress Aflatoxin Production and Growth of Aspergillus flavus on Coix lacryma-jobi during Storage" Toxins 15, no. 1: 77. https://doi.org/10.3390/toxins15010077
APA StyleZhou, S., Yuan, Q.-S., Wang, X., Jiang, W., Ou, X., Yang, C., Gao, Y., Wang, Y., Guo, L., Huang, L., & Zhou, T. (2023). Volatiles from Pseudomonas palleroniana Strain B-BH16-1 Suppress Aflatoxin Production and Growth of Aspergillus flavus on Coix lacryma-jobi during Storage. Toxins, 15(1), 77. https://doi.org/10.3390/toxins15010077

